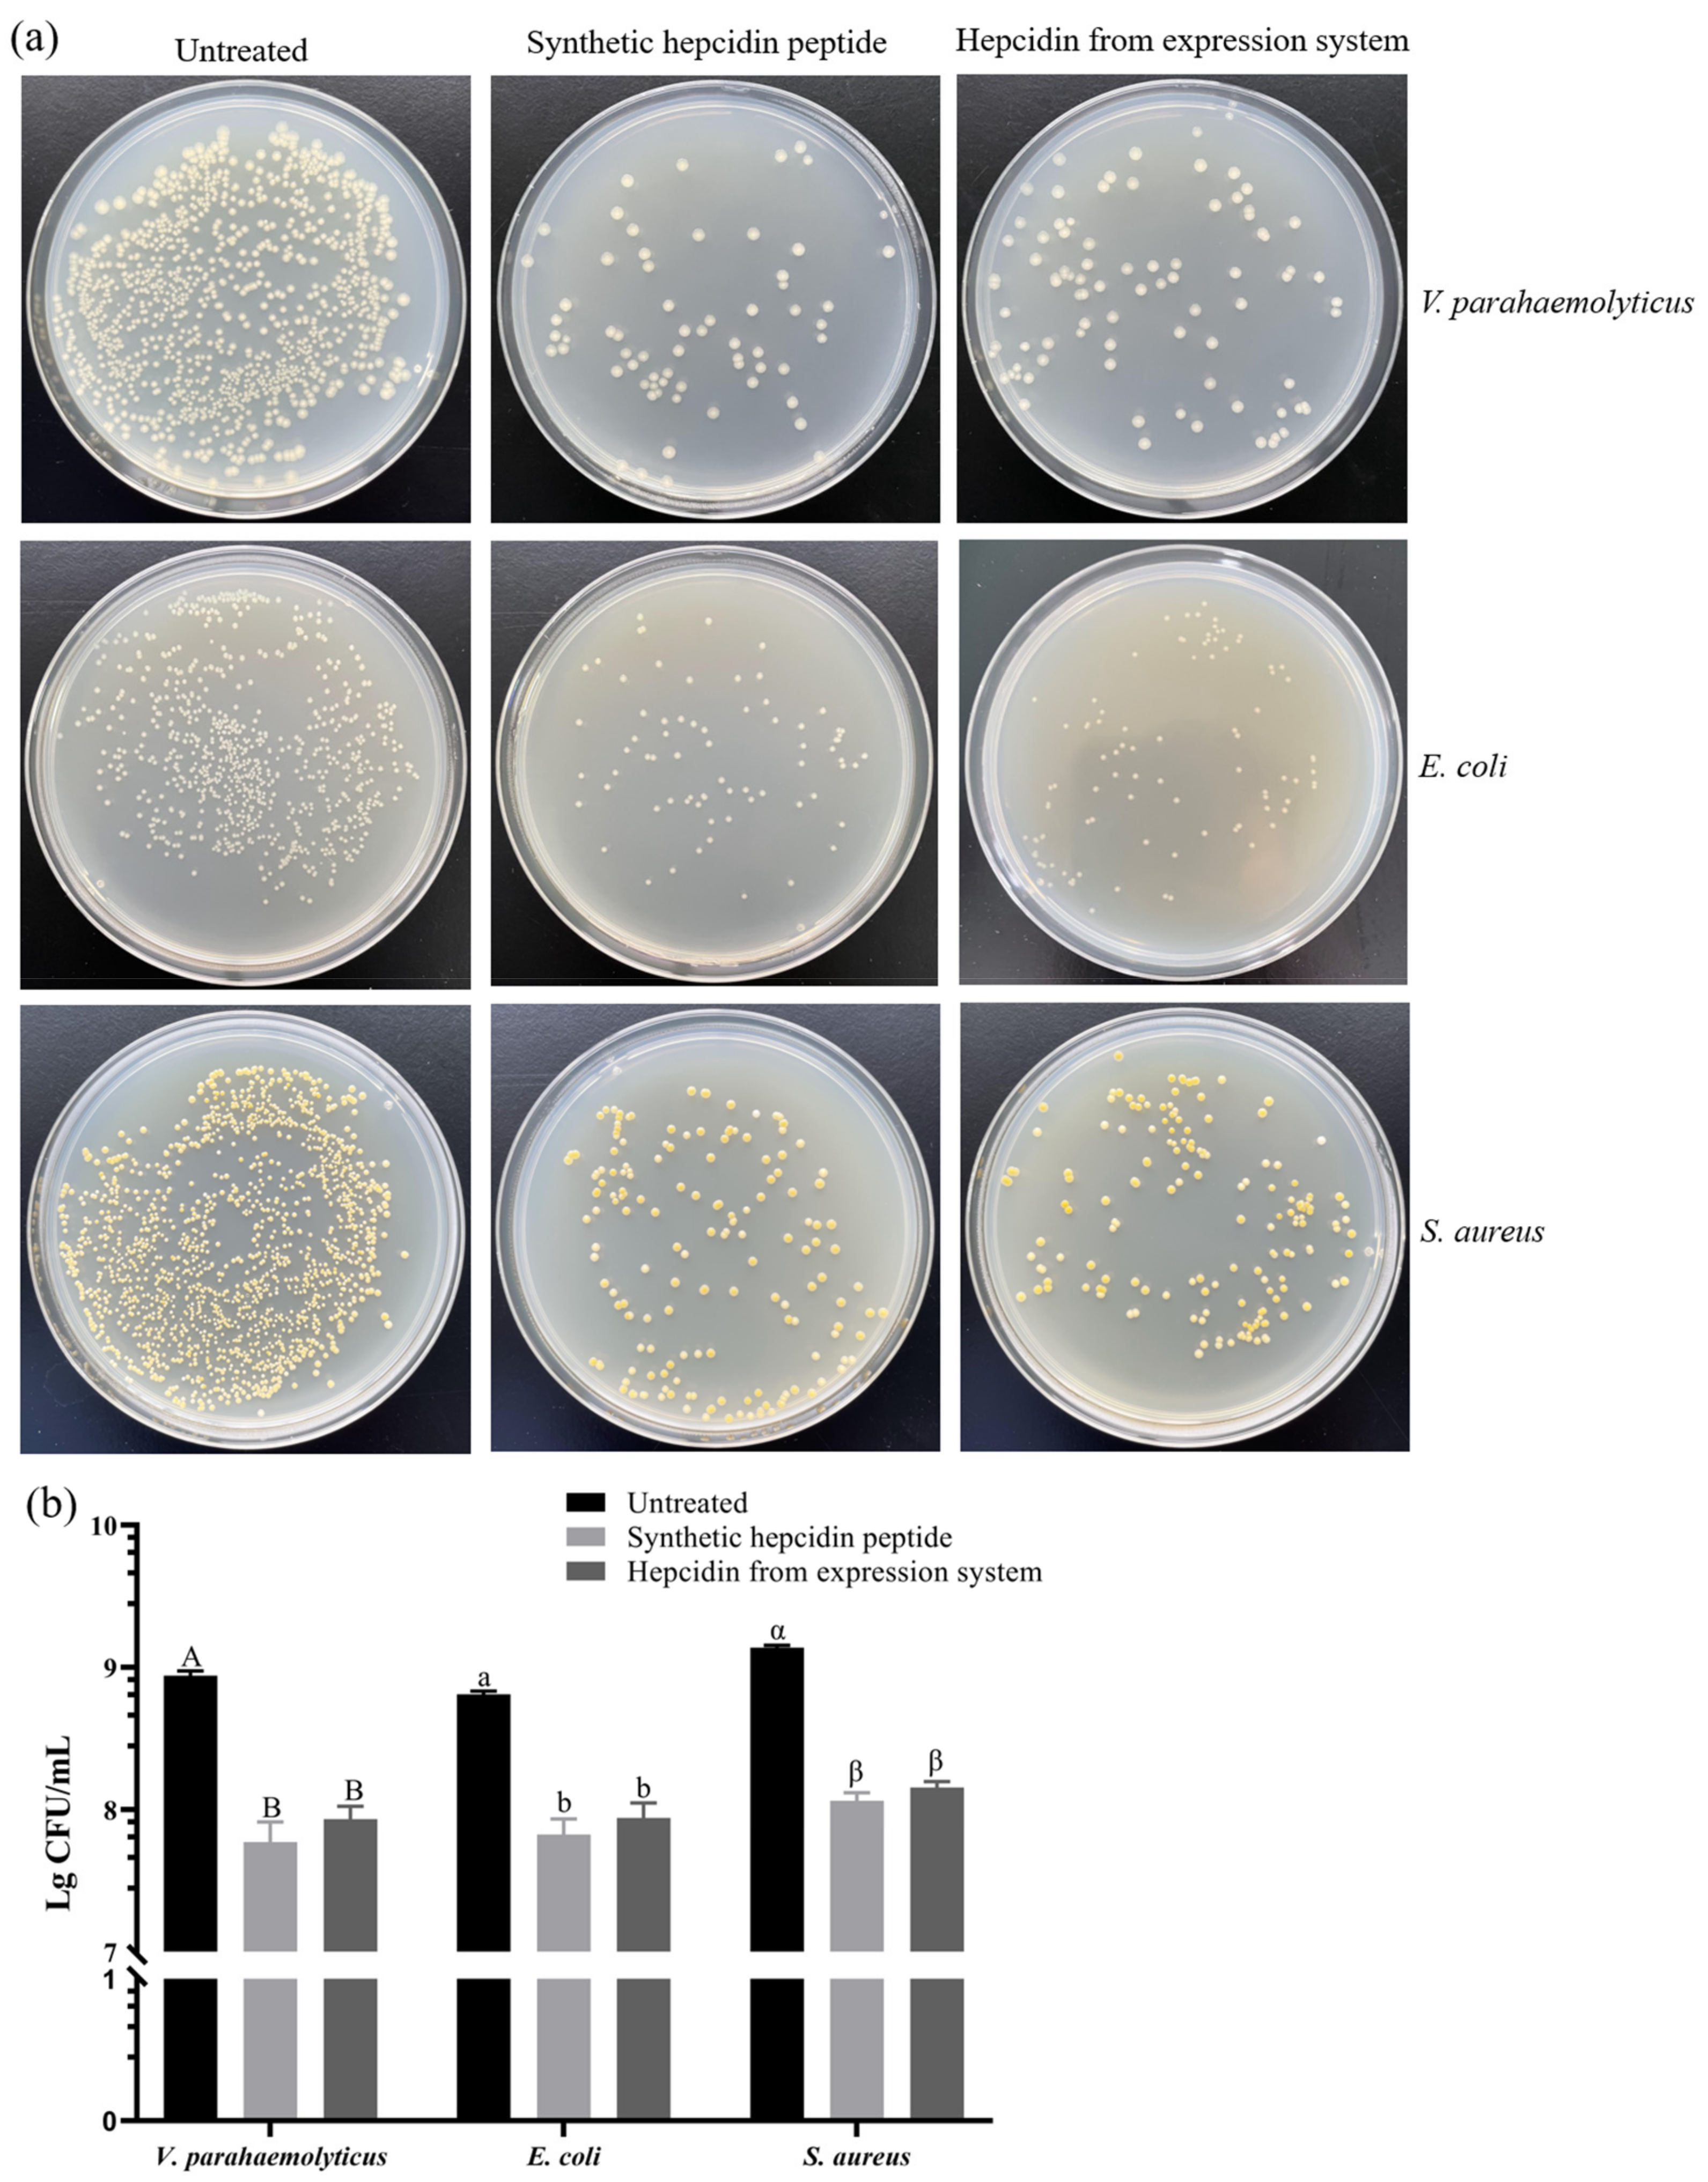
Cimb 45 00456 g005

Prokaryotic Expression, Purification, and Antibacterial Activity of the Hepcidin Peptide of Crescent Sweetlips (Plectorhinchus cinctus)
Abstract
:1. Introduction
2. Materials and Methods
2.1. Materials
2.2. Plasmid Constructs
2.3. Optimization of Induction Conditions
2.4. RSM
2.5. Purification of Recombinant Peptide
2.6. Western Blot Analysis
2.7. Cleavage of SUMO Fusions
2.8. Antibacterial Activity Assays
2.8.1. Minimum Inhibitory Concentration (MIC)
2.8.2. Colony Counting Assay
2.9. Statistical Analyses
3. Results
3.1. Construction of the Recombinant Plasmid Expressing of Hepcidin Peptide
3.2. Effect of Culture Mediums on the Expression of Recombinant Hepcidin Peptide
3.3. Effect of IPTG Concentration, Induction Time, and Induction Temperature on the Expression of Recombinant Hepcidin Peptide
3.4. Optimization of Induction Conditions by RSM
3.5. Purification of Recombinant Peptide
3.6. Cleavage of the Fusion Tag
3.7. Antibacterial Activity of Recombinant Protein
3.7.1. MIC
3.7.2. Colony Counting Assay
4. Discussion
5. Conclusions
Supplementary Materials
Author Contributions
Funding
Institutional Review Board Statement
Informed Consent Statement
Data Availability Statement
Conflicts of Interest
References
- Athira, P.P.; Anooja, V.V.; Anju, M.V.; Neelima, S.; Archana, K.; Muhammed Musthafa, S.; Antony, S.P.; Bright Singh, I.S.; Philip, R. A hepatic antimicrobial peptide, hepcidin from Indian major carp, Catla catla: Molecular identification and functional characterization. J. Genet. Eng. Biotechnol. 2022, 20, 49. [Google Scholar] [CrossRef]
- Wang, Y.; Liu, X.; Ma, L.; Yu, Y.; Yu, H.; Mohammed, S.; Chu, G.; Mu, L.; Zhang, Q. Identification and characterization of a hepcidin from half-smooth tongue sole Cynoglossus semilaevis. Fish Shellfish Immunol. 2012, 33, 213–219. [Google Scholar] [CrossRef]
- Moon, W.J.; Hwang, D.K.; Park, E.J.; Kim, Y.M.; Chae, Y.K. Recombinant expression, isotope labeling, refolding, and purification of an antimicrobial peptide, piscidin. Protein Expr. Purif. 2007, 51, 141–146. [Google Scholar] [CrossRef]
- Huang, T.; Gu, W.; Wang, B.; Zhang, Y.; Cui, L.; Yao, Z.; Zhao, C.; Xu, G. Identification and expression of the hepcidin gene from brown trout (Salmo trutta) and functional analysis of its synthetic peptide. Fish Shellfish Immunol. 2019, 87, 243–253. [Google Scholar] [CrossRef] [PubMed]
- Wang, K.-J.; Cai, J.-J.; Cai, L.; Qu, H.-D.; Yang, M.; Zhang, M. Cloning and expression of a hepcidin gene from a marine fish (Pseudosciaena crocea) and the antimicrobial activity of its synthetic peptide. Peptides 2009, 30, 638–646. [Google Scholar] [CrossRef] [PubMed]
- Chi, J.-R.; Liao, L.-S.; Wang, R.-G.; Jhu, C.-S.; Wu, J.-L.; Hu, S.-Y. Molecular cloning and functional characterization of the hepcidin gene from the convict cichlid (Amatitlania nigrofasciata) and its expression pattern in response to lipopolysaccharide challenge. Fish Physiol. Biochem. 2015, 41, 449–461. [Google Scholar] [CrossRef] [PubMed]
- Yin, X.; Chen, N.; Mu, L.; Bai, H.; Wu, H.; Qi, W.; Huang, Y.; Jian, J.; Wang, A.; Ye, J. Identification and characterization of hepcidin from Nile Tilapia (Oreochromis niloticus) in response to bacterial infection and iron overload. Aquaculture 2022, 546, 737317. [Google Scholar] [CrossRef]
- Li, Z.; Hong, W.S.; Qiu, H.T.; Zhang, Y.T.; Yang, M.S.; You, X.X.; Chen, S.X. Cloning and expression of two hepcidin genes in the mudskipper (Boleophthalmus pectinirostris) provides insights into their roles in male reproductive immunity. Fish Shellfish Immunol. 2016, 56, 239–247. [Google Scholar] [CrossRef]
- Cai, S.; Wang, J.; Wang, K.; Chen, D.; Dong, X.; Liu, T.; Zeng, Y.; Wang, X.; Wu, D. Expression, Purification and Antibacterial Activity of NK-Lysin Mature Peptides from the Channel Catfish (Ictalurus punctatus). Appl. Sci. 2016, 6, 240. [Google Scholar] [CrossRef]
- Gaglione, R.; Pane, K.; Dell’Olmo, E.; Cafaro, V.; Pizzo, E.; Olivieri, G.; Notomista, E.; Arciello, A. Cost-effective production of recombinant peptides in Escherichia coli. New Biotechnol. 2019, 51, 39–48. [Google Scholar] [CrossRef]
- Li, Y. Carrier proteins for fusion expression of antimicrobial peptides in Escherichia coli. Biotechnol. Appl. Biochem. 2009, 54, 1–9. [Google Scholar] [CrossRef]
- Kovalskaya, N.; Hammond, R.W. Expression and functional characterization of the plant antimicrobial snakin-1 and defensin recombinant proteins. Protein Expr. Purif. 2009, 63, 12–17. [Google Scholar] [CrossRef] [PubMed]
- Li, Y. Recombinant production of antimicrobial peptides in Escherichia coli: A review. Protein Expr. Purif. 2011, 80, 260–267. [Google Scholar] [CrossRef] [PubMed]
- Wood, D.W. New trends and affinity tag designs for recombinant protein purification. Curr. Opin. Struct. Biol. 2014, 26, 54–61. [Google Scholar] [CrossRef] [PubMed]
- Qu, H.; Chen, B.; Peng, H.; Wang, K. Molecular Cloning, Recombinant Expression, and Antimicrobial Activity of EC-hepcidin3, a New Four-Cysteine Hepcidin Isoform from Epinephelus coioides. Biosci. Biotechnol. Biochem. 2013, 77, 103–110. [Google Scholar] [CrossRef]
- Tao, Y.; Zhao, D.-M.; Wen, Y. Expression, purification and antibacterial activity of the channel catfish hepcidin mature peptide. Protein Expr. Purif. 2014, 94, 73–78. [Google Scholar] [CrossRef]
- Azaman, S.N.A.; Ramakrishnan, N.R.; Tan, J.S.; Rahim, R.A.; Abdullah, M.P.; Ariff, A.B. Optimization of an induction strategy for improving interferon-α2b production in the periplasm of Escherichia coli using response surface methodology. Biotechnol. Appl. Biochem. 2010, 56, 141–150. [Google Scholar] [CrossRef]
- Papaneophytou, C.; Kontopidis, G. A comparison of statistical approaches used for the optimization of soluble protein expression in Escherichia coli. Protein Expr. Purif. 2016, 120, 126–137. [Google Scholar] [CrossRef]
- Tarahomjoo, S.; Bandehpour, M.; Aghaebrahimian, M.; Ahangaran, S. Soluble Diphtheria Toxin Variant, CRM 197 was Obtained in Escherichia coli at High Productivity Using SUMO Fusion and an Adjusted Expression Strategy. Protein Pept. Lett. 2022, 29, 350–359. [Google Scholar] [CrossRef]
- Behravan, A.; Hashemi, A. RSM-based Model to Predict Optimum Fermentation Conditions for Soluble Expression of the Antibody Fragment Derived from 4D5MOC-B Humanized Mab in SHuffle™ T7 E. coli. Iran. J. Pharm. Res. IJPR 2021, 20, 254–266. [Google Scholar] [CrossRef]
- Zhou, X.; Chen, S.; Lu, F.; Guo, K.; Huang, L.; Su, X.; Chen, Y. Nematotoxicity of a Cyt-like protein toxin from Conidiobolus obscurus (Entomophthoromycotina) on the pine wood nematode Bursaphelenchus xylophilus. Pest Manag. Sci. 2021, 77, 686–692. [Google Scholar] [CrossRef] [PubMed]
- Al-Mohammadi, A.-R.; Osman, A.; Enan, G.; Abdel-Shafi, S.; El-Nemer, M.; Sitohy, M.; Taha, M.A. Powerful Antibacterial Peptides from Egg Albumin Hydrolysates. Antibiotics 2020, 9, 901. [Google Scholar] [CrossRef]
- Lai, D.; Zhou, A.; Tan, B.K.; Tang, Y.; Sarah Hamzah, S.; Zhang, Z.; Lin, S.; Hu, J. Preparation and photodynamic bactericidal effects of curcumin-β-cyclodextrin complex. Food Chem. 2021, 361, 130117. [Google Scholar] [CrossRef] [PubMed]
- Zamani, M.; Berenjian, A.; Hemmati, S.; Nezafat, N.; Ghoshoon, M.B.; Dabbagh, F.; Mohkam, M.; Ghasemi, Y. Cloning, Expression, and Purification of a Synthetic Human Growth Hormone in Escherichia coli Using Response Surface Methodology. Mol. Biotechnol. 2015, 57, 241–250. [Google Scholar] [CrossRef]
- Kanno, A.I.; Leite, L.C.d.C.; Pereira, L.R.; de Jesus, M.J.R.; Andreata-Santos, R.; Alves, R.P.d.S.; Durigon, E.L.; Ferreira, L.C.d.S.; Gonçalves, V.M. Optimization and scale-up production of Zika virus ΔNS1 in Escherichia coli: Application of Response Surface Methodology. AMB Express 2019, 10, 1. [Google Scholar] [CrossRef]
- Ren, J.; Zhao, M.; Shi, J.; Wang, J.; Jiang, Y.; Cui, C.; Kakuda, Y.; Xue, S.J. Optimization of antioxidant peptide production from grass carp sarcoplasmic protein using response surface methodology. LWT Food Sci. Technol. 2008, 41, 1624–1632. [Google Scholar] [CrossRef]
- Ghoshoon, M.B.; Berenjian, A.; Hemmati, S.; Dabbagh, F.; Karimi, Z.; Negahdaripour, M.; Ghasemi, Y. Extracellular Production of Recombinant l-Asparaginase II in Escherichia coli: Medium Optimization Using Response Surface Methodology. Int. J. Pept. Res. Ther. 2015, 21, 487–495. [Google Scholar] [CrossRef]
- Chouaibi, M.; Boussaid, A.; Donsì, F.; Ferrari, G.; Hamdi, S. Optimization of the Extraction Process by Response Surface Methodology of Protein Isolate from Defatted Jujube (Zizyphus lotus L.) Seeds. Int. J. Pept. Res. Ther. 2019, 25, 1509–1521. [Google Scholar] [CrossRef]
- Zhao, M.-X.; Chi, Z.; Chi, Z.-M.; Madzak, C. The simultaneous production of single-cell protein and a recombinant antibacterial peptide by expression of an antibacterial peptide gene in Yarrowia lipolytica. Process Biochem. 2013, 48, 212–217. [Google Scholar] [CrossRef]
- Maharani, R.; Hidayat, A.T.; Sabana, I.R.; Firdausi, A.; Aqmarina, A.; Kurnia, D.Y.; Amrullah, M.H.; Zainuddin, A.; Harneti, D.; Nurlelasari, D.H.; et al. Synthesis, Antioxidant Activity, and Structure–Activity Relationship of SCAP1 Analogues. Int. J. Pept. Res. Ther. 2021, 27, 17–23. [Google Scholar] [CrossRef]
- Bych, K.; Mikš, M.H.; Johanson, T.; Hederos, M.J.; Vigsnæs, L.K.; Becker, P. Production of HMOs using microbial hosts—From cell engineering to large scale production. Curr. Opin. Biotechnol. 2019, 56, 130–137. [Google Scholar] [CrossRef] [PubMed]
- Sadr, V.; Saffar, B.; Emamzadeh, R. Functional expression and purification of recombinant Hepcidin25 production in Escherichia coli using SUMO fusion technology. Gene 2017, 610, 112–117. [Google Scholar] [CrossRef] [PubMed]
- Gerardi, G.; Biasiotto, G.; Santambrogio, P.; Zanella, I.; Ingrassia, R.; Corrado, M.; Cavadini, P.; Derosas, M.; Levi, S.; Arosio, P. Recombinant human hepcidin expressed in Escherichia coli isolates as an iron containing protein. Blood Cells Mol. Dis. 2005, 35, 177–181. [Google Scholar] [CrossRef]
- Ma, Y.; Kim, S.-S.; Kwag, D.-G.; Kim, S.-H.; Kim, M.-S.; Ryu, S.-H.; Lee, D.-H.; So, J.-H.; Nam, B.-H.; Kim, Y.-O.; et al. High-Level Expression and Purification of Tag-free Peptides Containing Multiple Disulfide Bond in Pichia pastoris. Bull. Korean Chem. Soc. 2018, 39, 213–219. [Google Scholar] [CrossRef]
- Ting, C.-H.; Pan, C.-Y.; Chen, Y.-C.; Lin, Y.-C.; Chen, T.-Y.; Rajanbabu, V.; Chen, J.-Y. Impact of Tilapia hepcidin 2-3 dietary supplementation on the gut microbiota profile and immunomodulation in the grouper (Epinephelus lanceolatus). Sci. Rep. 2019, 9, 19047. [Google Scholar] [CrossRef] [PubMed]
- Srinivasulu, B.; Syvitski, R.; Seo, J.K.; Mattatall, N.R.; Knickle, L.C.; Douglas, S.E. Expression, purification and structural characterization of recombinant hepcidin, an antimicrobial peptide identified in Japanese flounder, Paralichthys olivaceus. Protein Expr. Purif. 2008, 61, 36–44. [Google Scholar] [CrossRef] [PubMed]
- Azari, M.; Asad, S.; Mehrnia, M.R. Heterologous production of porcine derived antimicrobial peptide PR-39 in Escherichia coli using SUMO and intein fusion systems. Protein Expr. Purif. 2020, 169, 105568. [Google Scholar] [CrossRef]
- Zuo, X.; Li, S.; Hall, J.; Mattern, M.R.; Tran, H.; Shoo, J.; Tan, R.; Weiss, S.R.; Butt, T.R. Enhanced Expression and Purification of Membrane Proteins by SUMO Fusion in Escherichia coli. J. Struct. Funct. Genom. 2005, 6, 103–111. [Google Scholar] [CrossRef]
- Yao, D.; Fan, J.; Han, R.; Xiao, J.; Li, Q.; Xu, G.; Dong, J.; Ni, Y. Enhancing soluble expression of sucrose phosphorylase in Escherichia coli by molecular chaperones. Protein Expr. Purif. 2020, 169, 105571. [Google Scholar] [CrossRef]
- Kaur, G.; Cheung, H.-C.; Xu, W.; Wong, J.V.; Chan, F.F.; Li, Y.; McReynolds, L.; Huang, L. Milligram scale production of potent recombinant small interfering RNAs in Escherichia coli. Biotechnol. Bioeng. 2018, 115, 2280–2291. [Google Scholar] [CrossRef]
- Gutiérrez-González, M.; Farías, C.; Tello, S.; Pérez-Etcheverry, D.; Romero, A.; Zúñiga, R.; Ribeiro, C.H.; Lorenzo-Ferreiro, C.; Molina, M.C. Optimization of culture conditions for the expression of three different insoluble proteins in Escherichia coli. Sci. Rep. 2019, 9, 16850. [Google Scholar] [CrossRef] [PubMed]
- Firatligil-Durmus, E.; Evranuz, O. Response surface methodology for protein extraction optimization of red pepper seed (Capsicum frutescens). LWT Food Sci. Technol. 2010, 43, 226–231. [Google Scholar] [CrossRef]
- Hadj Sassi, A.; Trigui-Lahiani, H.; Abdeljalil, S.; Gargouri, A. Enhancement of solubility, purification and inclusion-bodies-refolding of an active pectin lyase from Penicillium occitanis expressed in Escherichia coli. Int. J. Biol. Macromol. 2017, 95, 256–262. [Google Scholar] [CrossRef] [PubMed]
- Naz, F.; Asad, M.; Malhotra, P.; Islam, A.; Ahmad, F.; Hassan, M.I. Cloning, Expression, Purification and Refolding of Microtubule Affinity-Regulating Kinase 4 Expressed in Escherichia coli. Appl. Biochem. Biotechnol. 2014, 172, 2838–2848. [Google Scholar] [CrossRef] [PubMed]
- Andersen, K.R.; Leksa, N.C.; Schwartz, T.U. Optimized E. coli expression strain LOBSTR eliminates common contaminants from His-tag purification. Proteins Struct. Funct. Bioinform. 2013, 81, 1857–1861. [Google Scholar] [CrossRef] [PubMed]

| Source | Sum of Squares | df | Mean Square | F Value | p-Value Prob > F | Significance |
|---|---|---|---|---|---|---|
| Model | 342.19 | 9 | 38.02 | 81.93 | <0.0001 | ** |
| A | 2.61 | 1 | 2.61 | 5.63 | 0.0495 | * |
| B | 0.51 | 1 | 0.51 | 1.10 | 0.3293 | |
| C | 42.09 | 1 | 42.09 | 90.70 | <0.0001 | ** |
| AB | 2.79 | 1 | 2.79 | 6.01 | 0.0440 | * |
| AC | 2.74 | 1 | 2.74 | 5.90 | 0.0455 | * |
| BC | 2.37 | 1 | 2.37 | 5.11 | 0.0583 | |
| A2 | 65.72 | 1 | 65.72 | 141.61 | <0.0001 | ** |
| B2 | 89.03 | 1 | 89.03 | 191.83 | <0.0001 | ** |
| C2 | 104.24 | 1 | 104.24 | 224.62 | <0.0001 | ** |
| Residual | 3.25 | 7 | 0.46 | |||
| Lack of Fit | 2.23 | 3 | 0.74 | 2.91 | 0.1645 | not significant |
| Pure Error | 1.02 | 4 | 0.26 | |||
| Cor Total | 345.44 | 16 |
Disclaimer/Publisher’s Note: The statements, opinions and data contained in all publications are solely those of the individual author(s) and contributor(s) and not of MDPI and/or the editor(s). MDPI and/or the editor(s) disclaim responsibility for any injury to people or property resulting from any ideas, methods, instructions or products referred to in the content. |
© 2023 by the authors. Licensee MDPI, Basel, Switzerland. This article is an open access article distributed under the terms and conditions of the Creative Commons Attribution (CC BY) license (https://creativecommons.org/licenses/by/4.0/).
Share and Cite
Wang, P.; Lin, Z.; Lin, S.; Zheng, B.; Zhang, Y.; Hu, J. Prokaryotic Expression, Purification, and Antibacterial Activity of the Hepcidin Peptide of Crescent Sweetlips (Plectorhinchus cinctus). Curr. Issues Mol. Biol. 2023, 45, 7212-7227. https://doi.org/10.3390/cimb45090456
Wang P, Lin Z, Lin S, Zheng B, Zhang Y, Hu J. Prokaryotic Expression, Purification, and Antibacterial Activity of the Hepcidin Peptide of Crescent Sweetlips (Plectorhinchus cinctus). Current Issues in Molecular Biology. 2023; 45(9):7212-7227. https://doi.org/10.3390/cimb45090456
Chicago/Turabian StyleWang, Peixin, Zhongjing Lin, Shaoling Lin, Baodong Zheng, Yi Zhang, and Jiamiao Hu. 2023. "Prokaryotic Expression, Purification, and Antibacterial Activity of the Hepcidin Peptide of Crescent Sweetlips (Plectorhinchus cinctus)" Current Issues in Molecular Biology 45, no. 9: 7212-7227. https://doi.org/10.3390/cimb45090456
APA StyleWang, P., Lin, Z., Lin, S., Zheng, B., Zhang, Y., & Hu, J. (2023). Prokaryotic Expression, Purification, and Antibacterial Activity of the Hepcidin Peptide of Crescent Sweetlips (Plectorhinchus cinctus). Current Issues in Molecular Biology, 45(9), 7212-7227. https://doi.org/10.3390/cimb45090456










